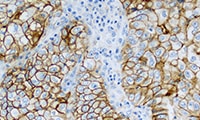
PD-L1 IHC 22C3 pharmDx product image

PD-L1 IHC 22C3 pharmDx on Dako Omnis for NSCLC

PD-L1 is a proven biomarker for NSCLC patients
- KEYTRUDA is the first and only anti-PD-1 monotherapy approved to treat metastatic NSCLC at first line—see the KEYTRUDA product label for details1,2,3
- Tumor PD-L1 overexpression is a biomarker for response to anti-PD-1 therapy—in a KEYTRUDA clinical trial, 57% of patients with NSCLC had tumors that exhibited PD-L1 expression4,5,6,7
- IHC testing for PD-L1 expression enables identification of patients most likely to benefit from PD-1 checkpoint inhibitors
- Pembrolizumab (KEYTRUDA) is a category 1* recommendation for metastatic NSCLC patients who express ≥ 50% PD-L1—the highest National Comprehensive Cancer Network® (NCCN®) category of evidence and consensus8
- In first-line treatment: Recommended for patients with
PD-L1 expression levels ≥ 50% when test results for sensitizing EGFR mutations, ALK rearrangements, ROS1 rearrangements, and BRAF V600E mutations are negative or unknown - In subsequent therapy: Recommended as a treatment option for patients with PD-L1 expression levels ≥ 1%, if pembrolizumab not previously given
* Category 1: Based upon high-level evidence, there is uniform NCCN consensus that the intervention is appropriate.
† Consider rebiopsy if appropriate. If repeat biopsy is not feasible, plasma testing should be considered.

Intended Use
PD-L1 IHC 22C3 pharmDx (Dako Omnis) is a qualitative immunohistochemical assay using Monoclonal Mouse Anti-PD-L1, Clone 22C3 intended for use in the detection of PD-L1 protein in formalin-fixed, paraffin-embedded (FFPE) non-small cell lung cancer (NSCLC) tissue, using EnVision FLEX visualization system on Dako Omnis.
PD-L1 protein expression is determined by using Tumor Proportion Score (TPS), which is the percentage of viable tumor cells showing partial or complete membrane staining at any intensity.
PD-L1 IHC 22C3 pharmDx (Dako Omnis) is indicated as an aid in identifying NSCLC patients for treatment with KEYTRUDA® (pembrolizumab) monotherapy. See the KEYTRUDA® product label for expression cutoff values guiding therapy in specific clinical circumstances guiding PD-L1 testing.
KEYTRUDA is a registered trademark of Merck Sharp & Dohme Corp., a subsidiary of Merck & Co., Inc.
References
1. PD-L1 IHC 22C3 pharmDx (Dako Omnis) [package insert]. Carpinteria, CA: Dako, Agilent Pathology Solutions; 2018.
2. Keytruda [package insert]. Hoddesdon, UK: Merck Sharp & Dohme Limited; 2018.
3. European Commission approves KEYTRUDA® (pembrolizumab) for first-line treatment of patients with metastatic non-small cell lung cancer (NSCLC) whose tumors have high PD-L1 expression with no EGFR or ALK positive tumor mutations [news release]. Kenilworth, NJ; Merck & Co., Inc.; January 31, 2017. http://www.mrknewsroom.com/news-release/oncology-newsroom/european-commission-approves-keytruda-pembrolizumab-first-line-treatm. Accessed December 21, 2017.
4. Garon EB, Rizvi NA, Hui R, et al. Pembrolizumab for the treatment of non-small-cell lung cancer. N Engl J Med. 2015;372(21):2018-2028.
5. Herbst RS, Baas P, Kim DW, et al. Pembrolizumab versus docetaxel for previously treated, PD-L1-positive, advanced non-small-cell lung cancer (KEYNOTE-010): a randomised controlled trial. Lancet. 2016;387(10027):1540-1550.
6. Reck M, Rodríguez-abreu D, Robinson AG, et al. Pembrolizumab versus chemotherapy for PD-L1-positive non-small-cell lung cancer. N Engl J Med. 2016;375(19):1823-1833.
7. Data on file. Merck & Co., Inc.
8. Referenced with permission from the NCCN Clinical Practice Guidelines in Oncology (NCCN Guidelines®) for Non-Small Cell Lung Cancer V.1.2018. © National Comprehensive Cancer Network, Inc. 2017. All rights reserved. Accessed December 21, 2017. To view the most recent and complete version of the guideline, go online to www.NCCN.org. National Comprehensive Cancer Network® (NCCN®) makes no warranties of any kind whatsoever regarding their content, use or application and disclaims any responsibility for their application or use in any way.